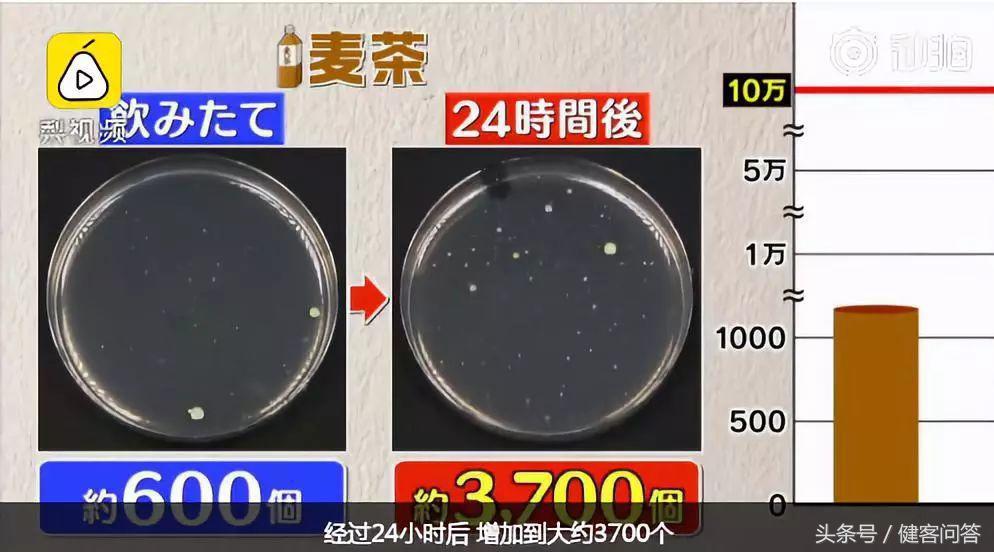
有趣的科学小实验冲牛奶,关于喝饮料的研究报告
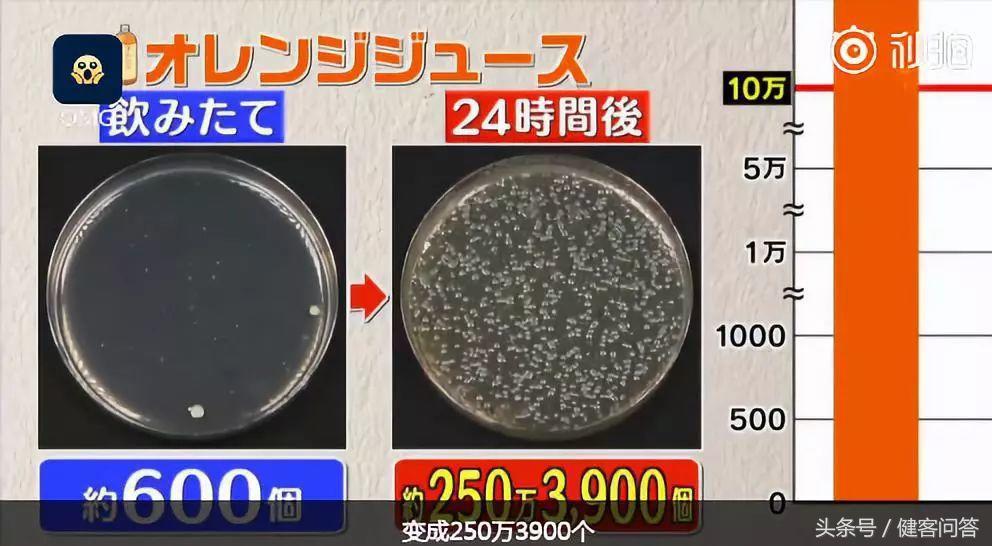
有趣的科学小实验冲牛奶,关于喝饮料的研究报告
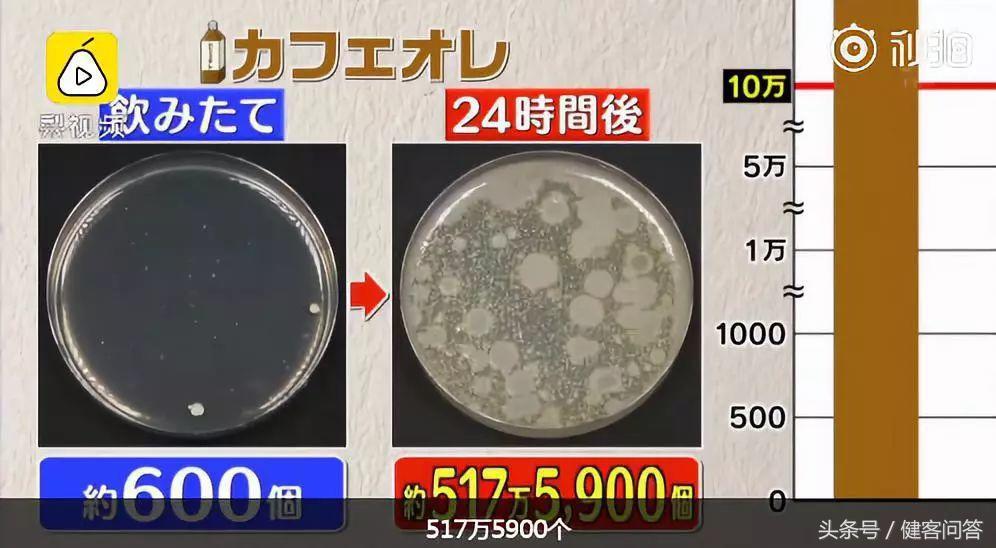
有趣的科学小实验冲牛奶,关于喝饮料的研究报告

地球人很爱喝饮料,尤其是在夏天。即使没有沙滩足球,没有碧海蓝天,没有美女帅哥,但只要一杯饮料和一台空调,也可以很幸福。
然而一个有趣的实验告诉大家,喝饮料也要有正确操作,如果忽视了这一点,到时候开盖的饮料不一定有奖,而是会有一支庞大的细菌家族等着你。
我们一直被细菌包围
打开一瓶饮料,喝上几口,黏在嘴唇和口腔上的金黄色葡萄球菌会通过唾液和饮料中的水流进行交换,进入到瓶子里面。
作为居于人类最常见的感染菌榜中的第二位,金黄色葡萄球菌仅次于大肠杆菌。它藏匿在各种食物中,比如牛奶、肉食类、剩饭剩菜等,可以使人化脓感染,引起肺炎、尿毒症等疾病。
当然,生活在我们周围的金黄色葡萄球菌并不可能让我们受到生命威胁。只有1克食品含量中有10万个以上的细菌才就会引起食物中毒的可能。
看到这里,你们会觉得,10万个细菌要多长时间才可以达到。不要怀疑细菌的繁衍能力,只要吃好睡好,一天之内也可以给大家创造奇迹。
这次的实验选取了六种不同种类的饮料,分别是水、绿茶、大麦茶、纯橙汁、可乐和牛奶咖啡。在保证每瓶饮料最初的细菌为600个左右后,喝上一口,盖上盖子后分别放在28℃的房间里,在24小时后进行细菌数的检测。

图片来源:微博截图
经过一天的放置时间,到底哪一瓶饮料含的细菌数量是最少的呢?
第一名:绿茶
细菌数量:最初的600个,下降到490个。

图片来源:微博截图
绿茶中因为含有儿茶酚,它具有抑菌作用,能抑制细菌繁殖,细菌因缺少营养成分所以无法生存,数量比前一天有所下降。
第二名:水

图片来源:微博截图
细菌数量:最初的600个,上升到1100个。
水因为没有其他营养成分,所以细菌增长的速度比较缓慢。
第三名:大麦茶
图片来源:微博截图
细菌数量:最初的600个,上升到3700个。
大麦茶的营养不算丰富,甚至味道有点苦涩,细菌也不太爱吃这种味道。
第四名:可乐

图片来源:微博截图
细菌数量:最初的600个,上升到249万3800个。
喝过可乐的人都知道,因为里面加入了不少的糖分,所以喝起来甜甜的。这种味道不仅我们喜欢,细菌也爱吃。有了自己喜欢吃的食物,当然是不停地生长发育、不停地繁衍后代了。
第五名:纯橙汁
图片来源:微博截图
细菌数量:最初的600个,上升到250万3900个。
纯橙汁虽然里面没有添加人工甜剂,但因为果汁里面含有果糖,对细菌来说,味道都是一样的,都很爱吃。
第六名:咖啡牛奶
图片来源:微博截图
细菌数量:最初的600个,上升到517万5900个。
这个爆炸式的增长,除了咖啡含有糖分之外,牛奶也有丰富的营养物质——蛋白质。在细菌看来,蛋白质和糖分就是无可抗拒的绝世美食,食物越多,自然就会容易滋长。
看完这个实验结果,小编完全被吓懵了,在温度设定为28℃的环境下,只是喝了一口立马盖上盖子,第二天瓶子里就已经繁殖那么多的细菌。如果温度再高一点,不管是食物还是饮料,那细菌生长的数量岂不是比实验结果更加令人吃惊?所以在这里要提醒大家,在备餐的时候应根据每个人的数量和食量来安排,一次烹饪的食物不宜太多,既不浪费食物,也避免产生大量的细菌。